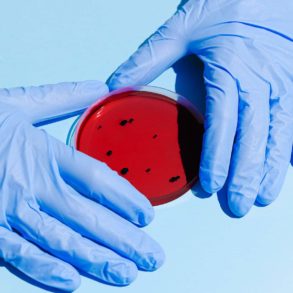

Brno, August 13 (BD) – The Czech Republic files a lawsuit against the European Union directive on firearms demanding it to be revoked, Czech news website iDnes.cz reported this week.
The directive bans long and short-barreled semi-automatic weapons with larger magazines, arms with foldable stocks and the ones converted from fully automatic weapons.
The new directive also demands people to register weapons that have been decommissioned or which are historical replicas.
EU has proposed the new laws in order to tighten the illegal trade and make tracking weapons easier.
Brussels said that the new measure would help to counter terrorist attacks in Europe making it harder to obtain guns.
Critics say that the directive only inhibits the market of legally held firearms and intrudes into internal affairs of the EU members. Moreover, Czechs have a long-held tradition of hunting deer. The new guidelines will heavily affect legal arm holders.
Every 33rd Czech has a legal firearm
The country has about 800 thousand weapons registered among 300 thousand permit holders with a total population of 10 million people. The country also allows 240 thousand gun owners to carry a concealed weapon for the purpose of defense, iDnes.cz reports.
“Such a massive punishment for decent weapon holders is unacceptable to us, because the prohibition of legally-held weapons has no connection with the fight against terrorism”, Milan Chovanec, Minister of Interior of the Czech Republic said for iDnes.cz.
He argues that it may negatively affect the country as a significant number of weapons will go to the black market.